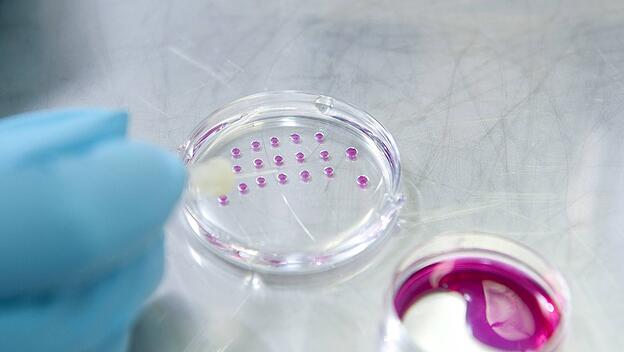

Die vollständige Trennung von Sexualität und Fortpflanzung ist Teil der transhumanistischen Agenda. Transhumanisten betrachten die In-Vitro-Fertilisation als ersten Schritt in diese Richtung, versuchen aber zusätzliche Technologien wie künstliche Gebärmutter, Klonen und eingeschlechtliche Fortpflanzung (weiter) zu entwickeln, um die Zeugung und Austragung von Kindern zukünftig von Geschlechtsakt und Mutterschaft zu trennen. Natürliche Vorgänge spielen dort keine Rolle mehr, wodurch die Frau als Mutter ebenso verschwindet, wie das als Geschenk empfangene Kind zum reinen Produkt wird.
In der kommenden Ausgabe der „Tagespost“ beschreibt die Bremer Sozialwissenschaftlerin Susanne Hartfiel, wo die Gemeinsamkeiten der Transgenderideologie und des Transhumanismus liegen. Beide betrachten das biologische Geschlecht als unzumutbare Einschränkung der menschlichen Freiheit und postulieren die freie Wählbarkeit des Geschlechts entlang eines Kontinuums von männlich bis weiblich. Susanne Hartfiel ist Autorin der Monografie „Die Neuerfindung des Menschen“ über Transhumanismus und Eugenik, die 2021 im Dominus Verlag erschien.
Die ersten Opfer der Ideologien sind Heranwachsende
Die ersten Opfer beider Ideologien sind Heranwachsende: Hartfiel verweist auf das vor etwa zehn Jahren erstmals aufgetretene Phänomen der „Rapid Onset Gender Dysphoria“: Nahezu über Nacht vervielfachte sich die Zahl der Kinder und Jugendlichen, meist Mädchen oder junge Frauen, die sich im falschen Körper wähnten und sogleich von Gleichaltrigen, Lehrern, LGBTQ-Aktivisten oder unkritischen Fachleuten in ihrer realen oder vermeintlichen Geschlechtsdysphorie bestärkt und zur Einnahme pubertätsblockender Hormone beziehungsweise hormoneller und chirurgischer Geschlechtsveränderungen ermutigt wurden.
In Deutschland schlägt sich die Transgenderideologie beispielsweise im vor Kurzem verabschiedeten Selbstbestimmungsgesetz nieder. Auch die Pläne der Ampelkoalition zur Änderung des Abstammungsrechts und zur Legalisierung von Eizellspende und Leihmutterschaft weisen transhumanistisches Gedankengut auf, in dem die Familie keine Rolle mehr spielt und das auf einem Menschenbild der technologischen Machbarkeit basiert. DT/fha
Lesen Sie den ausführlichen Beitrag in der kommenden Ausgabe der "Tagespost".